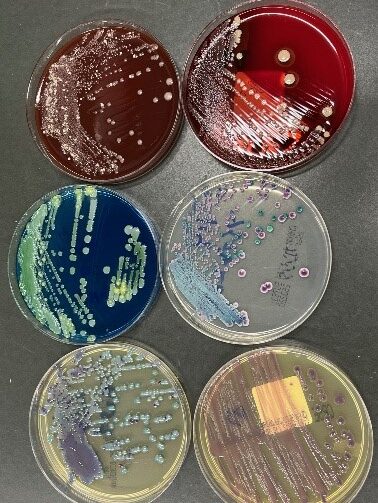

臨床検査部
部門紹介
臨床検査部は、患者さんに信頼され、安心して検査を受けていただけることを第一と考え業務を行っています。そのために、日々、知識・技術の向上に努め、迅速に質の高い検査結果を提供しています。
また、24時間体制で検査を実施しており、夜間や休日の緊急検査にも対応しています。
【スタッフ】
臨床検査技師 19名
業務紹介
採取された尿や血液を調べる検体検査部門(一般検査・生化学検査・血液検査・輸血検査・細菌検査・病理検査)と体に直接触れて調べる生体検査部門(心電図・超音波・脳波検査など)に分かれて業務を行っています。
また、診療支援の一環(タスクシェア)として採血室で看護師と共に外来患者さんの採血を行っています。
この他にも栄養サポートチーム(NST)、感染制御チーム(ICT)、抗菌薬適正使用支援チーム(AST)、糖尿病教室、心臓カテーテル検査・治療などのチーム医療にも積極的に参加し、多職種と連携してより良い医療の提供を目指しています。
検体検査部門
採血業務
外来採血室では看護師と臨床検査技師が採血業務を行っています。

一般検査
主に健康診断などでおなじみの尿検査や便潜血検査を行っています。
また、インフルエンザ、コロナ、アデノ、マイコプラズマや溶連菌などの各種ウイルス、細菌感染症の簡易検査を行い、臨床へ迅速に結果を報告しています。
髄液中の細胞数測定や、関節液の結晶検査、精液検査、便中卵検査も行っています。
 |
 |
 |
| 尿・尿中有形成分分析装置 | 尿沈査鏡検 | 感染症簡易検査 |
生化学・免疫検査
血液を遠心分離して得られる上清を用いて、肝機能、腎機能、脂質、電解質などの生化学項目をはじめ、肝炎ウイルス、梅毒などの感染症項目、腫瘍マーカー、甲状腺ホルモンなどの測定を行っています。検体搬送ラインを導入し業務の効率化を図り、迅速かつ正確な検査結果の提供に努めています。
 |
 |
 |
| 生化学自動分析装置 | 免疫検査 | 血液ガス分析 |
血液・凝固検査
血球成分の数やヘモグロビン濃度、凝固因子などを自動分析装置で測定しています。分析装置で異常となったものは顕微鏡で目視し、貧血の有無や種類、炎症や血液疾患の診断に役立てています。
 |
 |
 |
| 自動血球分析装置 | 凝固分析装置 | 血液像鏡検 |
輸血検査
安全な輸血のためにABO・Rh(D)式血液型検査、不規則抗体検査、交差適合試験などを行っています。また、血液製剤の発注・保管・管理・払い出しも行っており、24時間体制で緊急輸血に迅速に対応できるよう努めています。
 |
 |
 |
| 全自動輸血検査装置 | 交差適合試験(試験管法) | 血液製剤の保管、管理 |
細菌検査
細菌検査室は、ヒトに感染症を引き起こす細菌や真菌を特定し、その原因微生物に有効な薬剤を調べる部門です。
細菌検査室には、いろいろな検体が届きます。肺炎が疑われた場合には喀痰、膀胱炎が疑われた場合には尿、細菌性腸炎が疑われた場合には便、傷の化膿部位からは膿、その他にも血液、腹水、関節液、組織などさまざまです。それらの検査材料の中から病原菌を特定し、検出した菌に対する薬の効果(薬剤感受性)を調べます。
病原菌の特定、その菌に効果のある薬剤の報告は、診断・治療につながる重要な検査です。
さらに、感染対策チーム(ICT)や抗菌薬適正使用支援チーム(AST)などのチーム医療にも参加し、医師、看護師及び薬剤師とともに診療支援を行っています。
|
 |
 |
病理検査
病理検査室では、患者さんから採取された組織や細胞を調べ、病気の原因や状態を明らかにする検査を行っています。病理組織診断・細胞診断は、治療方針の決定に直結する重要な情報であり、医療を支える重要な役割を担っています。
当部門には、常勤病理医1名(病理専門医・細胞診専門医)、臨床検査技師3名(細胞検査士・認定病理検査技師)が在籍し、専門資格を有するスタッフが連携しながら、迅速かつ正確な診断を提供しています。
病理組織診検査
手術や生検で採取された組織を、固定・包埋・薄切・染色といった工程を経て、病理医が診断するために標本を作製します。
また、手術中に迅速に診断を行う術中迅速診断にも対応しており、執刀医と連携しながら治療方針の決定に貢献しています。
さらに、必要に応じて病理解剖も実施しています。病理解剖は、病気の原因や経過を明らかにし、医療の質向上や今後の診療に役立つ重要な業務です。

細胞診検査
喀痰、尿、婦人科検体など様々な部位から採取された細胞を顕微鏡で観察し、がんや炎症の有無を調べます。 細胞検査士がスクリーニングを行い、異常細胞を見逃さないよう丁寧に観察します。
細胞診は、がんの早期発見に大きく貢献する検査であり、臨床検査技師としての専門性を発揮できる分野です。

生体検査部門(生理機能検査)
心電図検査
心臓が動く際に発する微弱な電気信号を波形として記録し、心臓の状態をチェックする検査です。
〇検査項目
標準12誘導心電図検査、運動負荷心電図検査(マスター2階段法・トレッドミル法)、24時間心電図を記録するホルター心電図

血管機能検査
動脈血管壁の硬さや詰まり具合から、動脈硬化の程度を調べる検査です。
〇検査項目
血圧脈波検査(ABI/PWV)、皮膚還流圧検査(SPP)

呼吸機能検査
肺活量や気道の閉塞具合、酸素を体内に取り込む能力などを調べる検査です。喘息、慢性閉塞性肺疾患、間質性肺炎などの疾患が疑われるときや、経過観察のために行われます。
〇検査項目
肺活量、努力性肺活量、機能的残気量、肺拡散能、気道可逆性試験

超音波(エコー)検査
超音波検査とは、探触子(プローブ)から対象物に向けて超音波を送信し、帰ってくる反射波を画像化する検査です。非侵襲的な検査であり、体内の情報をリアルタイムに観察することができます。
〇検査項目
心エコー検査、血管エコー検査(頸動脈、下肢深部静脈、下肢動脈、腎動脈など)
 |
 |
| 心エコー | 下肢静脈エコー |
神経生理検査
全身の神経や筋肉は活動する際に微弱な電流が発生しています。また体の外からの刺激に反応して発生する電流もあります。この電流を体に取り付けた電極で捉えることで、脳、神経の状態を調べる検査です。
〇検査項目
脳波検査、神経伝導検査、大脳誘発電位検査(視覚誘発電位、体性感覚誘発電位)
 |
 |
| 脳波検査 | 神経伝導検査 |
耳鼻科領域の検査
耳の聞こえや鼓膜、平衡機能、睡眠時無呼吸、味覚障害などを調べる検査です。
〇検査項目
聴力検査、語音聴力検査、ティンパノグラム、補聴器適合検査、耳管機能検査、眼球運動検査、重心動揺検査、電気味覚検査、睡眠時無呼吸検査、聴性脳幹反応(ABR)検査
 |
| 聴力検査室 |
心臓カテーテル検査
医師、看護師、診療放射線技師と共にカテーテル検査・治療に携わっています。主な業務内容は、心電図・血圧・酸素飽和度のモニタリングとデータ管理です。

認定資格
・臨床検査技師:19名
・認定病理検査技師:1名
・細胞検査士:3名
・IAC(国際細胞検査士):1名
・認定心電検査師:3名
・認定超音波検査士(循環器):4名
・二級臨床検査士:1名
・NST専門療法士:2名
・石川県糖尿病療養指導士:2名
・第二種ME技術者:2名
・特定化学物質・アルキル鉛等作業主任者、有機溶剤作業主任者:2名
・医療安全管理者:2名
施設認定
・日本臨床細胞学会認定施設
教育・研究活動(2025年度)
〇学会発表
・第50回石川県医学検査学会 3症例
・第42回石川県臨床細胞学会 1症例
・第43回日本輸血・細胞治療学会北陸支部例会 1講演
〇論文・執筆
・「膀胱リンパ上皮腫癌の1例」 日本臨床細胞学会雑誌
〇その他
院内雑誌
・「能登半島震災後DVT検診活動参加報告」 公立能登総合病院
今後も積極的に情報発信を行い、医療の質向上に努めてまいります。
臨床検査技師を目指す皆様へ
当検査部では内部異動があります。数年単位で様々な経験をすることで、臨床検査技師として成長できると考えています。また、配置された部門で専門試験・認定試験の取得を目指し、他部門の専門試験でも本人の希望があれば積極的に応援します。
検査データは患者さんの命に直結するため、責任は大きいですが、その分やりがいも大きい仕事です。
興味があれば、是非、見学や実習で臨床検査部の現場を体験してみてください。
お問い合わせ先
〒926-0816
石川県七尾市藤橋町ア部6番地4
公立能登総合病院経営管理部総務課
電話 0767-52-8749
FAX 0767-52-9225
E-mail:syomu@noto-hospital.jp



